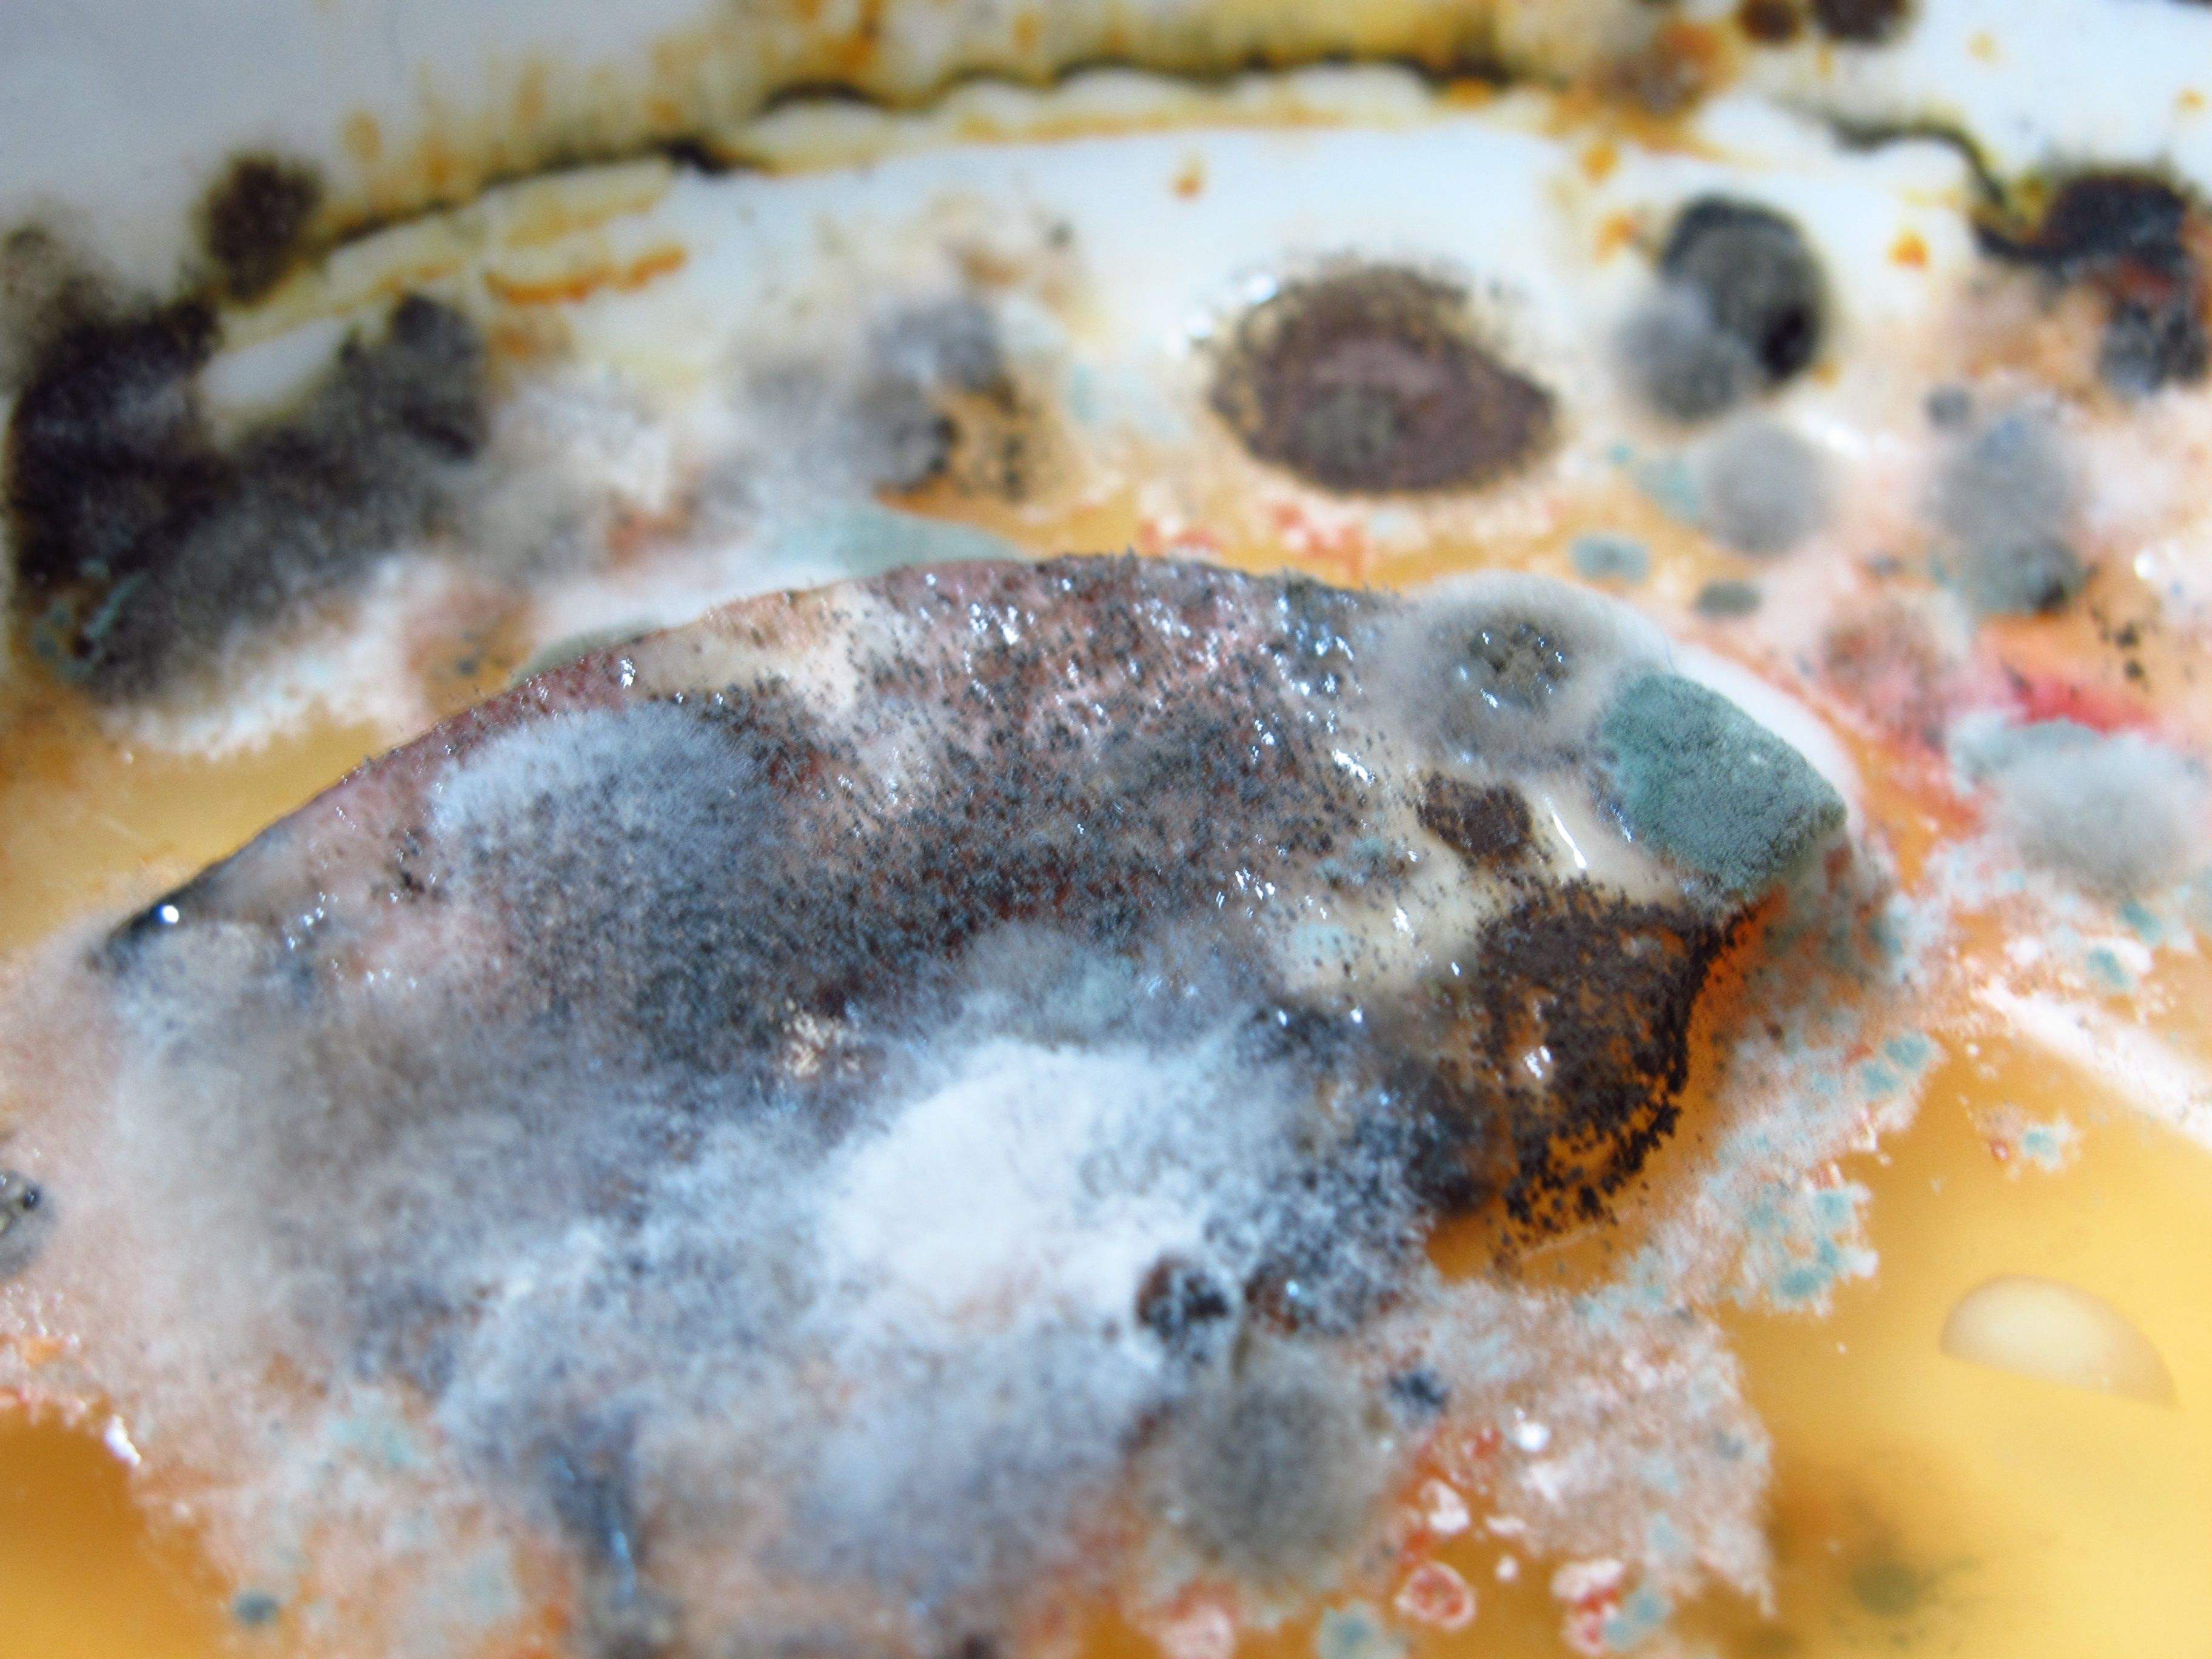
"五大点"告诉你怎么找出房屋管道漏水_霉菌

霉菌

如何控制霉菌污染食品?金华勇洁净车间臭氧杀菌处理!
图片尺寸1080x720
霉菌分类之菌落观察——超清的菌落照片(答案在p7)
图片尺寸950x605
什么因素促使面包霉菌生长最快?
图片尺寸640x427
霉菌.jpg
图片尺寸935x525
校考高分密码 | 素材分享-霉菌肌理.关键词:霉菌肌理,微观 - 抖音
图片尺寸1440x1924
厨房霉菌
图片尺寸640x427
险被漏诊的曲霉菌感染_分子诊断_中国卫生检验网——中国卫生检验杂志
图片尺寸500x539
在孟加拉红培养基上霉菌和酵母菌的形态是什么样的
图片尺寸2592x1944
微生物常见霉菌形态你了解多少帮你汇总好了
图片尺寸281x269
霉菌 图书
图片尺寸800x800
家里有霉菌怎么除掉
图片尺寸640x425
原创链接:次氯酸专题|酸性电解水让霉菌无处藏身!
图片尺寸449x309
【科普】霉菌的生活环境 - 知乎
图片尺寸1291x873
第一次拍霉菌
图片尺寸2048x1536
霉菌大 揭秘
图片尺寸2000x2667
专业解决细胞房微生物污染,包括霉菌,细菌,真菌,噬菌体等杂菌污染
图片尺寸4896x3672
有什么消毒剂可以快速彻底的清除霉菌吗? - 知乎
图片尺寸947x597
梅雨季节,谨防霉菌过敏!
图片尺寸500x337
衣柜容易发霉怎么处理呢臭氧除霉菌保护衣物免受侵害
图片尺寸1000x761
"五大点"告诉你怎么找出房屋管道漏水_霉菌
图片尺寸3648x2736